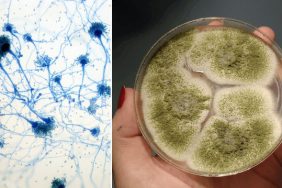
1ee82ba8-7b8pd4bl1fbovvs0ddnrjd

Hızlı Erişim
Son Dakika
Günün son gelişmelerine yakından bakın.
Döviz Kurlar
Piyasanın kalbine yakından göz atın.
Son Depremler
Kripto Paralar
Kripto para piyasalarında son durum!
Namaz Vakitleri
Emtia
Emtia'larda son durum!
Hava Durumu
Maç Merkezi
Puan Durumu
Gazeteler
Günün gazete manşetlerini inceleyin.
Canlı Tv
Covid 19
Pandeminin detayları..
Yol Durumu
Nöbetçi Eczaneler
Bildirimler